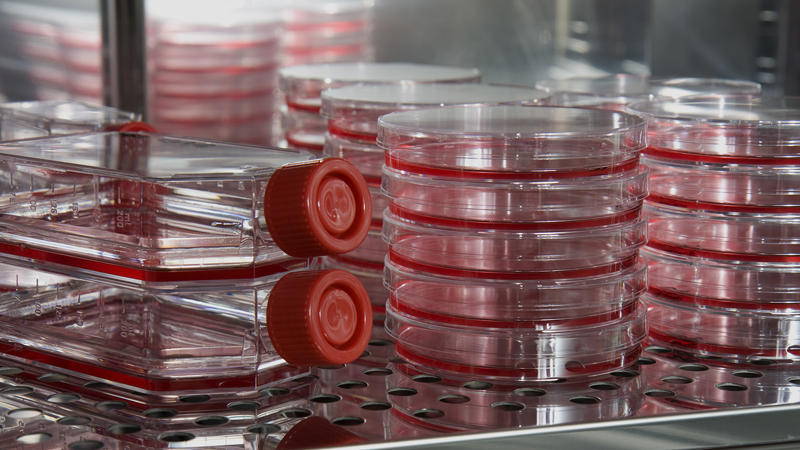
Petri Dishes

Blogs and cases
Blogs and customer cases

Warehouse Monitoring: Medical/Surgical Supply Distributor Improves Efficiency and Compliance
- Life Science
Owens & Minor, Mechanicsville, VA, is a leading U.S. supplier of medical and surgical products to hospitals, integrated healthcare systems...

Railway Operator Improves Safety with High-Quality Compressed Air
- Weather & Environment
High quality compressed air is indispensable to the reliability of railway operations. Harsh winters pose special challenges to maintaining this...

Dewpoint monitoring in OLED research
- Industrial Measurements
Adachi laboratory of Kuyshu University, Center for Future Chemistry, is using a Vaisala dewpoint transmitter for monitoring the H2O ppm level in...
21st century 4-stroke engine based power plants rely on Vaisala humidity measurement
- Power Generation and Transmission
Power plant emissions (especially nitrogen oxides) can be controlled by monitoring the humidity content of the engine charge air. An accurate...

Optimizing gas turbine performance with precise humidity measurements
- Industrial Manufacturing and Processes
- Power Generation and Transmission
Ensuring gas turbines run at maximum efficiency is a primary goal for operators. In the current economic climate, anything that increases...

Strong expertise from General Shale Brick
- Industrial Measurements
With facilities strategically located across the USA, General Shale Brick is one of the largest brick manufacturers in the country. The company...

Power Station Facelift
- Power Generation and Transmission
Hydrological measurement network delivered to Da Nhim, Vietnam The Da Nhim power station is located approximately 250 km northeast of Ho Chi...

Vaisala Humidity Measurement in Formula 1
- Industrial Measurements
- Road weather
Tires play a central role in the performance of all cars, but Formula 1 races have especially “educated” the general public about the importance...
Setting the standard in tissue engineering
- Life Science
Tissue engineering offers the promise of off-the-shelf products containing living human cells. Organogenesis Inc . has turned this science...

Vaisala to Deliver Lightning Detection Network to Poland
- Weather & Environment
- Meteorology
Vaisala has signed a contract to deliver and install a national lightning detection network in Poland, to be operated by the Polish National...

Mars Polar Lander Mission
- Industrial Measurements
- Space exploration
The landing vehicle of the Mars Polar Lander mission is equipped with FMI/GEO’s Finnish special measurement electronics, including two pressure...